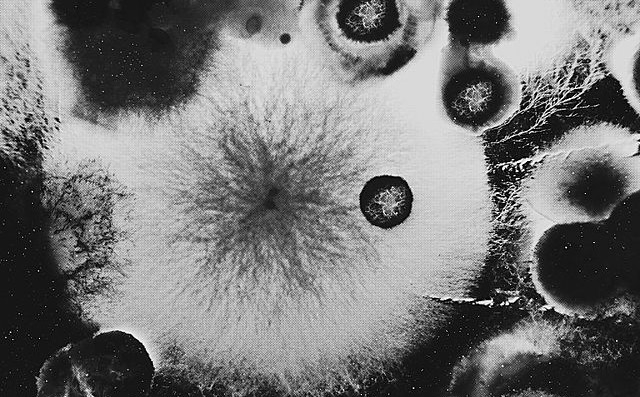

Dileme vsega živega
Dragi poslušalci, pozdravljeni v Objektu meseca. V današnji oddaji bo objekt namesto kamna celica. Skladno s tem se bomo spraševali: Kakšen material za umetniško kreacijo so celice in bakterije? In pa na kakšne načine uporabljajo umetniki tkivni inženiring za ustvarjanje svojih skulptur?
Celica namesto kamna ni naš objekt le po naključju. To je bil namreč naslov enega bolj oglaševanih dokumentarnih prispevkov na temo raziskovalne umetnosti ‒ pogosto imenovane tudi hibridna, intermedijska ali bioumetnost ‒ na naši nacionalki. Nastal je v času trajanja razstave Živi objekt v Mestni galeriji pred dvema letoma in zastavljal prav uvodni vprašanji. Pa sta tako vprašanji kot naslovna fraza nekoliko nerodna, celo zoprno antropocentrična. Človek je seveda nagnjen k razumevanju vsega kot materije za preoblikovanje, da pa se to pripisuje tudi umetnikom v polju raziskovalne umetnosti, je tema perečih razprav med njenimi akterji.
Nocoj bomo listali knjižico dilem, s katerimi se raziskovalna umetnost sooči, in poslušali, kako nanje odgovarja lokalna produkcijska platforma Zavod Kersnikova, specializirana za umetnost na presečišču z znanostjo. Knjižica pa je lani izdana publikacija z naslovom Life as an Object, ki so jo s partnerji pisali v okviru evropskega projekta Arc-hive. Pogovarjali smo z umetnikom in raziskovalcem, Guyem Ben-Aryjem, ter umetniškim vodjo Kersnikove, Jurijem Krpanom.
Raziskovalni umetniki se zelo dobro zavedajo, da mora polje tovrstnega ustvarjanja svoj vokabular še vzpostaviti, da bo zrelejše in zmožno uspešno komunicirati svoje bistvo tako javnosti kot stroki, med katerima deluje. Vedno znova jih namreč sprašujemo, na kakšen način se razlikujejo od znanstvenikov ter zakaj se pritožujejo nad poimenovanjem bioumetnost. Sprašujemo, kako neki se prodaja umetniško delo, ki bi zmoglo rasti v nepredvidene anomalije živega. Če se raziskovalna umetnost zaradi svojih specifik res ne more logično vključiti v obstoječi umetnostni kanon, kako bi bil torej zastavljen sistem za nemoteno raziskovanje živih interkraljestev?
Prva točka. Pogovoriti se moramo o biomedijski umetnosti.
Maja Smrekar po svojem dolgoletnem raziskovanju v okviru projekta K9 Topologija združi svojo celico s celico svoje psičke Ade in preizkuša nekonvencionalne metode reprodukcije. S Špelo Petrič v projektu PL’AI opazujemo igro z žogo med umetno inteligenco in vrtno rastlino. Zoran Srdić ustvari objekt s funkcionalno in avtonomno gibalno mišico, ki se imenuje Biobot. Glasbilo CellF ‒ delo Guya Bena Arya ‒ , na katerega igrajo nevralna tkiva, nastopi v duetu s človeškim solistom. To so le nekateri projekti, ki so nastali v laboratoriju BioTehna Zavoda Kersnikova in so bili tudi predstavljeni v pripadajoči galeriji Kapelica. Raziskovalni umetniki v svojem delu z znanostjo sodelujejo tako, da vanj vključujejo žive organizme. V gledalčevo polje vidnega postavljajo obstoječe in nove oblike živih bitij. Ob tem poudarjajo svoje premišljevanje antropocena in nasprotovanje objektivizaciji, na katerega sta namigovali v začetku zastavljeni vprašanji.
Ne gre pozabiti, da ima vse živo vzpostavljene sebi lastne hierarhije in organizacijske sisteme. Omenjeni projekti so si med sabo izredno različni. Pri delu vseh umetnikov je sicer bistveno že omenjeno sodelovanje z živo prezenco, ki pa ni univerzalna ali naključna. Zato ima umetnost, ki jo zanima živost vseh oblik in vrst, težave z artikuliranjem raznolikosti svojih interesov.
Kadar se naštete projekte enači s pojmom sodobne bioumetnosti, se ob tem vse živo zvede na generično. Da živo ne bi postalo zgolj simbolično in posledično lažje objektivizirano, morajo hierarhije ter razlike ostati jasne. Priljubljeno ameriško poimenovanje bioart je naštete umetnike v institucijah sodobne vizualne umetnosti predstavilo kot enoten fenomen. V svoje razstave jih povabijo v enakih kontekstih, čeprav gre za vsaj tri popolnoma različne poetike, pristope, angažmaje, tehnike in konec koncev etike. Nadgrajena različica imena, ki se glasi biomedijska umetnost, pa je nerodna, saj implicira medijsko členitev umetnosti, ki v polju raziskovalne umetnosti ni pomembna. Vsa ta poimenovanja preprečujejo, da bi se gledalec v dela primerno poglobil. Prav zato se raziskovalno umetnost, čeprav obravnava aktualne, lahko bi rekli mainstream problematike sodobnega sveta, v splošni javnosti jemlje kot umetnost za posvečene.
Naloga najti skupno ime za vse te prakse ‒ kadar je to potrebno ‒ in obenem komunicirati raznolikost polja, je torej zelo zahtevna, a pomembna. Kersnikova je skupno vizijo ter odgovor poskušala najti na številnih dogodkih, med drugim na neskončno dolgem – spletnem – simpoziju v sklopu projekta Life as an object. Med podanimi predlogi so na primer: life art, metabolic art, micro performativity ter eden izvirnejših, moist media. Z vsemi naštetimi in tistimi, ki so ušli naši raziskavi, se želijo približati artikulaciji živega, hkrati pa nikakor zapreti svojega polja z definicijo – torej izrazom, ki sam po sebi pomeni omejitev. Z zadnjim povedanim pa nam je lahko veliko bolj jasna tudi inherentna težava z vizijo pregledne artikulacije v namerno nedefiniranem polju.
Druga točka. Pogovoriti se moramo o živem.
Poleg poimenovanja je pogosto težko najti tudi mejo med živimi in neživimi entitetami. Nekateri raziskovalci namreč obravnavajo mrtva telesa, v katerih bi žive celice nemara še lahko delovale. Geologe je moč spravit v zadrego z vprašanjem, kako živi so lišaji. Mladen Dolar je v delu O glasu živo zamejil na tisto, kar ima zmožnost glasu. Pojem življenja pa lahko zaide tudi v metafiziko ali ezoteriko, kjer so kot živi lahko obravnavani tudi kristali ali pokrajina. Praksa Kersnikove odgovarja, da je bistveno obravnavati vsako od naštetih možnosti, saj si umetnost lahko privošči prav to nedoločljivost. Prav umetnik se namreč lahko sooči s tesnobo nedefiniranosti. Ta sposobnost znanosti, utemeljeni na merljivosti, manjka. Jurij Krpan dodatno poudarja, da se izkustvo in empatija do živega vzpostavljata prav telesno. Ravno s telesom je moč problematizirati antropocentrizem in premišljevati njegove alternative. Nedoločljivost pa se širše pogosto kaže kot kontroverznost, ki bega mnoge.
Pomemben vir kontroverznosti je zagotovo etika, ki naj bi bila v raziskovalni umetnosti prevpraševana na dnevni ravni. Pa vendar je mnenje Kersnikove, da etika v projektu trpi le takrat, ko se živo v umetniškem delu instrumentalizira.
Obstoj molekularnih senzibilitet, kot jih imenuje Maja Smrekar, namreč omogoča zaporedje korakov, ki jih enakovredno izvajajo vse sodelujoče živosti. Morda bi se lahko zazdelo, da umetniki mikrocelične strukture objektivizirajo, saj jih ločujejo od izvornega konteksta in jih postavljajo na ogled v novo vzpostavljena umetna okolja. To je do določene mere sicer res – umetniki v raziskavi živo izvzamejo iz prvotnega konteksta ter morajo zato vzpostaviti nove, umetne kontekste, ki bodo vnaprej zagotavljali ta obstoj. Laboratoriji, objekti in instalacije pomenijo nujno infrastrukturo, pa vendar lahko nanje gledamo drugače kot zgolj na apropriacijo, ob katero se površna artikulacija tako rada zatakne. Lahko jih vidimo kot izrazito enakopravno vzpostavljena okolja sobivanja. V njih entiteta mikroživega postane vidna ter spodbudi prakso skrbi in vzdrževanja. Pomembno je izpostaviti, da ne gre za enosmerno prehajanje prostorov, saj je tudi umetnik tisti, ki svoje celice, krvne vzorce ter tkiva predaja in sprejema. Tako prihaja do izmenjav, ki v nevarnost tveganja lastne živosti postavlja oba ali več udeleženih v procesu. Tudi človeška entiteta, ki jo artikuliramo z nazivom umetnik, je tista, ki mora zdržati konceptualen ali fizičen vnos sebi tujega ter prilagoditi svoj biološki sistem. Primer tovrstnega sobivanja bi lahko našli v delu Made a horse live in me umetniškega dueta Art Orienté Objet, v katerem je umetnica v svoj sistem sprejela konjsko kri. Anafilaktični šok, ki lahko ob takšni hibridizaciji nastane, človeka potencialno ubije hitreje kot izstrelek iz pištole.
Tretja točka. Kako pojmovati ustvarjene hibride kot ne le žive, temveč umetniške entitete?
Raziskovalna umetnost v glavnem teži stran od imperativa totalnosti objekta ter zaključenosti, ki jo ta narekuje. Tudi če je v posameznih fazah projekta predstavljen objekt, je zanj ključna procesualnost, oziroma, kot jo imenujejo avtorji sami, mikroperformativnost. Tudi na Kersnikovi imperativ zaključenega umetniškega objekta pojmujejo kot medijskost, ki je priljubljen način klasifikacije v umetnosti in po njihovem mnenju nepomembna razsežnost. V kaj se potemtakem materializira umetniški proces, ki temelji na trenutku obstoja?
Predstavitev minljivih umetnostnih oblik je poseben kuratorski izziv, in to se vidi prav v dejstvu, da se pogosto konča prav v razstavljanju objektov, ki so bili v nekem performativnem dejanju uporabljeni. V belih vitrinah so predstavljeni kot dokazno gradivo, opremljeni s forenzičnim merilom, na katerem so izpisani avtor, lokacija ter datum. V takšnih primerih se javnost težko zaveda, da objekti, ki jih ponavadi vidimo v črni, dramatično osvetljeni kocki Galerije Kapelica niso umetnina sama. Tudi zgodovinjenje takšne umetnosti hitro zdrsne v prej omenjeno fetišizacijo predmetnosti, uporaba videa pa izgubi za performans značilno sočasnost z gledalcem. Jurij Krpan poudarja, da je bolj kot artefakti, dokumentacija in videi pomembna prav začasna skupnost, ki se vzpostavi ob performativnem dejanju.
Objekte na razstavah pogosto vidimo tudi zato, ker je vrsta performativnosti, o kateri je govora, zelo specifična. Od ostalih oblik performativnosti se razlikuje v tem, da je tisti del, ki ga vidi gledalec, pogosto zelo kratkotrajen, čeprav je proces priprave trajal več mesecev, včasih let. Prav tako je povečini ključna fizična prisotnost celičnih struktur, katerih performativnost že zaradi svoje mikrovelikosti za človeško percepcijo časa nima dovolj očitnih učinkov. Ta prezenca ima zato zaenkrat nerešeno pomanjkljivost: ni dovolj teatralna, da bi se zmogla postaviti na ogled svojemu gledalcu. Umetniki se zato poslužujejo različnih načinov predstavitve svojih uvidov: performativnosti, objektnosti, teatralnosti, pa tudi eksperimentalnih ali konvencionalnih likovnih oblik. Maja Smrekar v projektu K9 topologija oblečena v živalsko kožo sobiva s pasjo vrsto. Guy Ben-Ary ustvarja glasbene instrumente, dvakrat večje od svojega telesa, čeprav jih uglašuje kvadratni centimeter velika laboratorijska posodica nevronskega tkiva.
Uprizoritev raziskovalne umetnosti je tehnično najzahtevnejša takrat, ko umetnik razstavlja aktivno in živečo obliko. Institucije, ki omogočajo vzpostavitve funkcionalnega živečega umetniškega sistema, so redke. S tem pa tudi možnosti tamkajšnje žive uprizoritve.
Kersnikova ima poleg galerije vzpostavljene tri laboratorije ter zaposlene strokovnjake raznolikih inženirskih področij. Laboratorij znotraj institucije je specifičen prostor, ki temelji na razumevanju in sposobnosti razreševanja potreb širokega razpona umetniških del. Umetnikovo ohranjanje dela v drugih institucijah, ki nimajo tovrstnih sterilnih prostorov, pomeni, da morajo biti umetniki prisotni ves čas priprave ter trajanja razstave. To pomeni tudi, da nimajo druge možnosti, kot razstavljati fizične laboratorije in se torej ne morejo izogniti laboratorijski estetiki ali pa morajo celične organizme izpostavljati neprimernim pogojem tranzita, ki ogrožajo njihov obstoj. Da bi pridobili več svobode in zmanjšali nivo človeškega truda, tako fizičnega kot psihičnega, intenzivno razvijajo avtomatizirana podporna okolja za oskrbo umetniških del, ki jih bo v veliki meri upravljala umetna inteligenca. Gostovanja so vseeno zahtevna naloga in zato težko obsojamo pomanjkanje predstavitev tovrstne umetnosti izven specifičnega strokovnega polja.
Ko je razstave v takšnem ali drugačnem kontekstu konec, je zanimivo vprašanje, kaj se zgodi z živim organizmom, ki je za čas priprave ter trajanja tako intenzivno vzdrževan. Je preprosto zavržen? Zdelo bi se pravično, da bi celica dočakala srečno upokojitev.
Četrta točka. Pogovoriti se moramo o arhiviranju.
Ohranjanje življenja do naravne smrti zahteva dodaten postprodukcijski sistem, ki trenutno v razvoju raziskovalne umetnosti povzroča še več nejasnosti kot predhodne stopnje procesa. Zanimivo pa je opazovati različne pristope, ki si jih umetniki izbirajo za ohranjanje svojih del. Ko je umetnica kolektiva Art Orienté Objet preživela krvno združitev z živalsko vrsto, je za arhivsko shrambo ostala fotografija telesa, ki o obstoju nevidne snovi v njej ne pove tako rekoč ničesar. Poleg nje so bile vidne nenavadno oblikovane proteze za hojo po galerijskem prostoru. Hibridna kri je bila zamrznjena in v steklenih epruvetah skrbno pospravljena v skrinje s suhim ledom, na piedestalu pa so ostale aluminijaste škatlice z vgraviranimi začetnicami avtorjev, v katere je bila pospravljena video in fotografska dokumentacija različnih oblik za različne video predvajalnike. Z vprašanjem ohranjanja umetniškega dela se poglobljeno ukvarja tudi Guy Ben-Ary.
Velik del publikacije Life as an Object se posveča iskanju primernih oblik shranjevanja performativne umetnosti različnih oblik živih sistemov. V teoretskih prispevkih in na podlagi primerov dobre prakse išče načine, ki bi bili bolj prilagodljivi sodobnim interdisciplinarnim praksam.
Klasična oblika administrativnega, preprosto rečeno papirnatega arhiva je sicer že doživela drastični preobrat z digitalizacijo ter je s premikom iz fizičnega v oblak omogočila mnoge nove, tudi začasne in izvenkontekstualne nivoje shranjevanja. Sodobni digitalni arhivi pa so še vedno rigorozno zakoreninjeni v svojih hierarhičnih ter časovnih strukturah, ki shranjujejo zgolj eno možnost dogodka. Trenutno pomembno vprašanje je, kako bi v kaosu takšnega arhiva sodobne umetnosti lahko delovala živeča biološka materija?
Avtomatizirano shranjevanje na internetu je povzročilo digitalno akumulacijo in drastično zmanjšalo zavestne odločitve o tem, česa se bomo spominjali in na kakšen način. Tudi arhivi umetnosti so poplave neselektivnega spomina, ki vključujejo mrežo dokumentacije, sestavljene iz vseh drobcev minule prisotnosti, od teoretskih omemb do memov in fotografij slabe resolucije. Projekt Life as an Object izpostavlja, da je zavestna odločitev spominjanja v novem arhivu nujno potrebna.
V performativnosti raziskovalne umetnosti je trenutek živosti ključen, zato se zdi vzpostavljanje digitalne platforme, ki bi v posnetke spakirala nekdanje živosti, ki so minljive že same po sebi, precej kontradiktorna dejavnost. Ida Hiršenfelder, zvočna umetnica in arhivarka v publikaciji Life as an object kot prvo izpostavi potrebo po mrežnem in diskurzivnem preoblikovanju arhiva. Fizični del arhiva bi tako vseboval pripovedovanja in pričevanja o fizični izkušnji vseh prisotnih v umetniškem delu. Enakopravno morajo biti zastopane vse žive entitete, tudi tiste najmanj znatne. Na ta način bi bile brskajočemu dostopne vzporedne, nelinearne časovnice. Maja Smrekar je v K9 topologiji opolnomočila arhivsko izkušnjo gledalca tako, da skozi množico referenčnega parabesedila, izjav, pisemskih korespondenc ter čutnih zaznav, kot sta tip in vonj, vzpostavlja kontinuirano bližino in na ta način omogoči vstop v zelo specifične trenutke svojega procesa.
Sodelujoči v projektu Life as an object si ga zamišljajo kot performativno dejanje – arhiv, ki je sam po sebi umetniški proces in ne nastane zgolj kot posledica dogodka. Na ta način bi se oddaljili od pasivnosti opazovanja, ki zbira dokaze zunaj sebe ter jih deponira v oblak, ter se približali obliki produkcije znotraj produkcije, ki zbira in oblikuje tudi nematerialne dele aktivnosti.
Peta točka. Zaključek, ki ni odgovor, temveč naše vprašanje.
Konteksti, v katerih potekajo hibridne raziskave raziskovalne umetnosti, so laboratoriji, vzpostavljeni pod natančno določenimi pogoji, med katerimi so sterilnost, temperatura in svetloba le najbolj očitni parametri. Nasprotno pa umetnik iz njih vsakodnevno izstopa v okolje, ki ga narekujejo kapitalistično naravnane politike. Vlečejo ga v polja birokracije, liberalno spreminjajo temeljne pogoje dela in prebadajo enakomernost procesa, prostora in časa, ki so potrebni za umetnostni proces. Bo tudi točka, v kateri se govori o finančnih pogojih nastanka takšnih mikroutopij, našla rešitev?
Lektorirala je Lara, tehniciral je Toljo, brala sta Muri in Špela.
vir fotografije: wikimedia commons

Dodaj komentar
Komentiraj